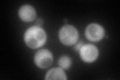
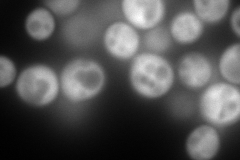
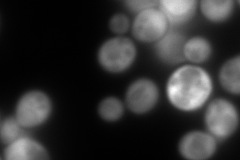
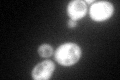
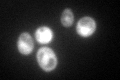

View description
Homoserine dehydrogenase (L-homoserine:NADP oxidoreductase), dimeric enzyme that catalyzes the third step in the common pathway for methionine and threonine biosynthesis; enzyme has nucleotide-binding, dimerization and catalytic regions
Localization:
Intensity:
Fold change:
Significance:
-
C’ GFP library in SD
cytosol144.22 -
N' NOP1pr-GFP in SD
cytosol512.625 -
N' TEF2pr-mCherry in SD
cytosol625.095 -
N' NATIVEpr-GFP in SD

cytosol251.003 -
N' TEF2pr-VC and Cyto-VN in SD

#N/A0 -
C’ GFP library in SD+DTT

cytosol123.830.85No -
C’ GFP library in SD+H2O2
cytosol161.81.12No -
C’ GFP library in Starvation Media
nucleusN/AN/AYes -
C’ GFP library on the background of Pup2-DaMP

cytosol -
C’ GFP library on the background of CCT mutant

cytosolN/AN/ANo
